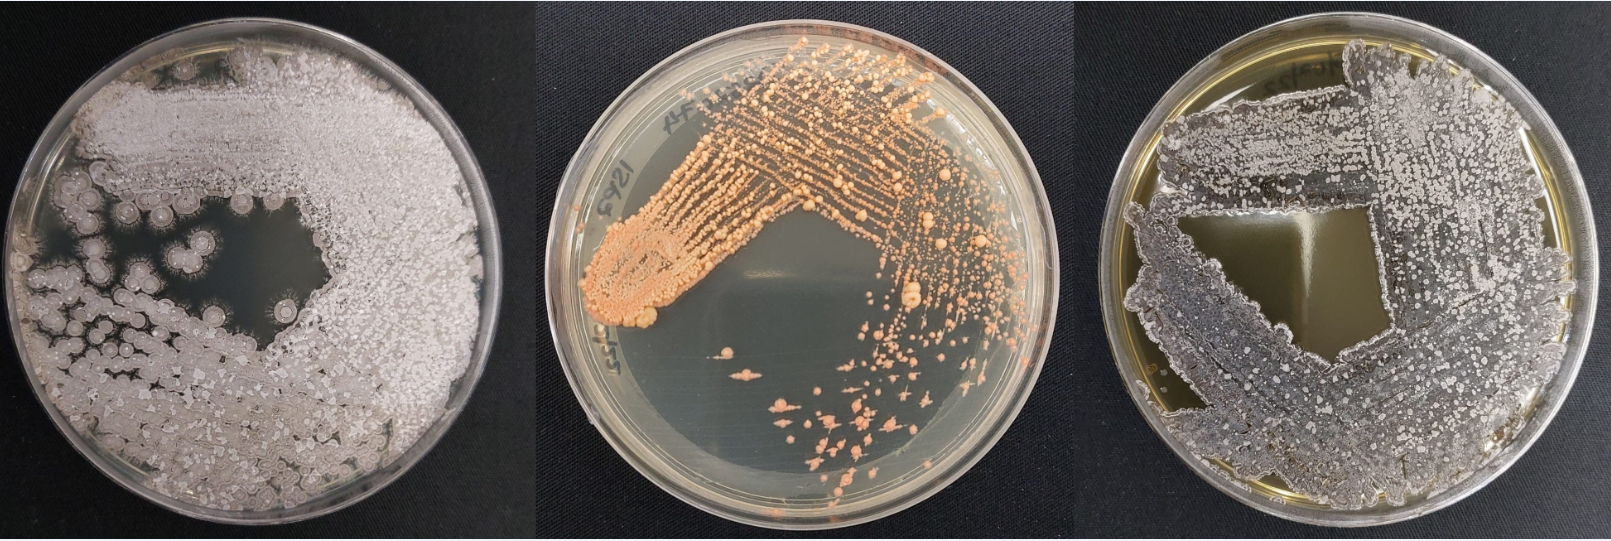

Next steps for USP PASS-CR scholar, Nirma Nadan
Nirma Nadan, one of our 2021 PASS-CR Scholars from the University of the South Pacific, Fiji, submitted her Masters thesis for examination last month. Her research examined the potential of beneficial rhizosphere Actinobacteria to manage the plant pathogenic bacteria that causes wilt in tomato, Ralstonia solanacearum. “My research aimed to manage the bacterial wilt disease affecting tomato using a biological control agent, which is a sustainable and ecofriendly approach” she added.
Nirma sampling tomato plants for isolation of beneficial bacteria
Actinobacteria are well-known plant growth promoting bacteria that have co-evolved with plants and they use many direct and indirect mechanisms to improve plant growth and supress pathogens. These bacteria can produce phytohormones like indole acetic acid, ammonia and siderophores, and can solubilise inorganic phosphate. These bacteria can suppress plant pathogens by producing compounds such as antibiotics, enzymes, toxins, antimicrobial peptides and bacteriocins. She says, “all these attributes of my research can help strengthen the food security and build resilience in the Pacific”.
During her research, Nirma isolated 90 strains of actinobacteria from the rhizosphere (the area or zone of soil surrounding a plant root) of tomato in Fiji.
Actinobacteria isolated from the rhizosphere of tomatoes in Fiji
She subjected these strains to a series of rigorous chemical tests including the assessment of antibacterial activity and plant growth promoting traits which included production of indole acetic acid, ammonia, hydrolytic enzymes and solubilisation of phosphate. She then shortlisted some excellent performers to challenge Ralstonia solanacearum and simultaneously evaluated the plant growth promoting traits of the best isolate in vitro and in the greenhouse.
One of her co-supervisors Dr Bree Wilson from the University of Southern Queensland (UniSQ) has undertaken similar work in Australia. “Nirma certainly had her work cut out for her, screening all of those isolates for their plant growth promoting and disease control properties. I think I can safely say on behalf of the supervision team Principal supervisor Dr Tamara Osborne and co-supervisor Dr Reema Prakesh (University of South Pacific) that we’re impressed with her persistence and research output”.
Nirma’s results are promising and she’s identified a clear winner for further research. Nirma has been busy preparing a manuscript for submission this month, which has been supported by the Research office at the University of South Pacific ‘Write-up Scholarship’.
She says “the scholarship supports students who have recently submitted their thesis to concentrate on writing manuscripts by providing a 3 month living allowance. I’m really grateful to USP to have received the scholarship and I’m looking forward to submitting my manuscript soon”.
Nirma Nadan and Dr Bree Wilson (UniSQ)
We asked Nirma what else she’s been up to since submitting, whilst waiting for receipt of examiners comments. “Apart from drafting the papers, I’ve been completing some short courses from International Training Centre (ITC) which is a training branch of International Labour Organisation (ILO). I have completed two courses on project procurement for agriculture and rural development and the project management cycle. This training is pivotal for filling the gaps in agricultural research. I am also currently enrolled in a course with ACIAR Learn on Monitoring, Evaluation and Learning (MEL) in Research. Developing MEL practice in research is a core skill of an effective researcher and I am grateful that ACIAR provides this opportunity to its alumni to further enhance their knowledge and skills through ACIAR Learn.”
We asked Nirma what was next in her science career. “I am hoping to develop professionally and provide my research expertise and knowledge towards enhancing food security and building resilience in the Pacific. There are many challenges emerging in the agriculture sector and our commitment towards research needs to grow as well so that the problems do not outpace the solutions. I’m considering undertaking a PhD and I’m currently exploring various project ideas”.